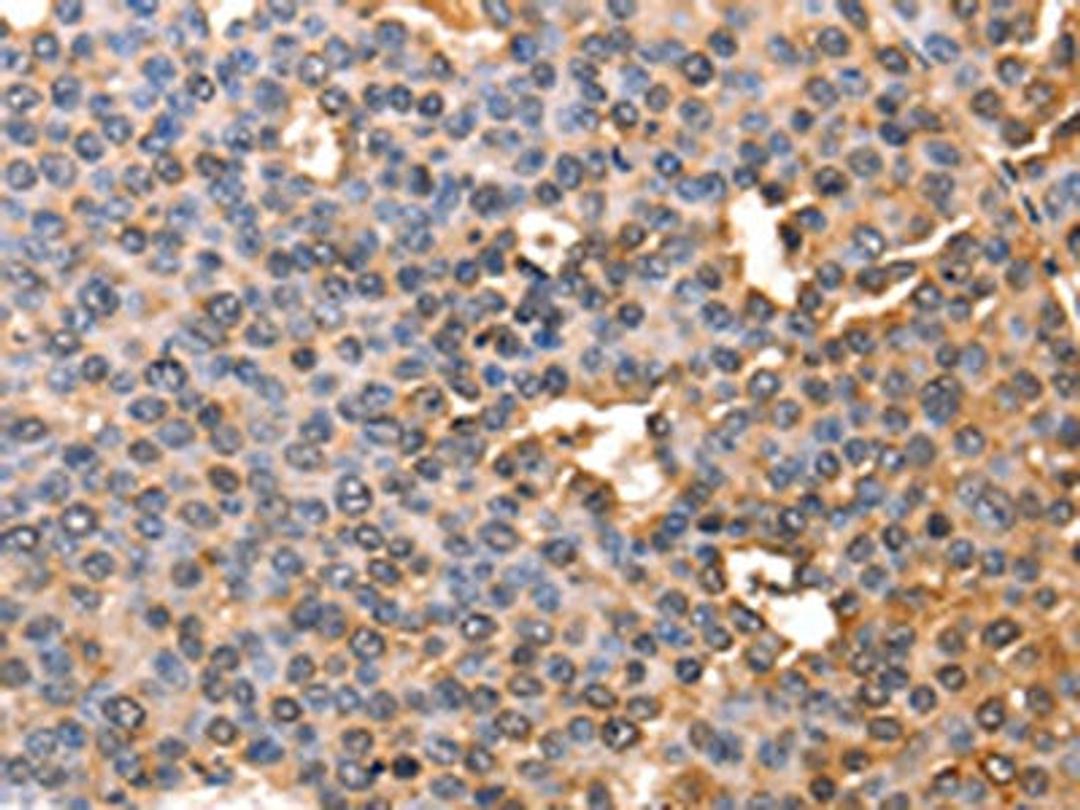

Product & ReviewsAntibodies
AFP Antibody
Product Details
- Cat. No.
- CSB-PA787484
- Type
- Primary Antibody
- Clonality
- Polyclonal
- Host
- Rabbit
Biological Information
- Clonality: Polyclonal
- Host: Rabbit
- Reactivity: Human
- Antigen: Fusion protein of Human AFP
- Clone: N/A
- Conjugate: Non-conjugated
- Isotype: IgG
- Modifications: Non-modification
- Source: Antigen affinity purification
- Gene: P02771
Handling
- Quantity: 100ul
- Storage: Upon receipt, store at -20°C or -80°C. Avoid repeated freeze.
- Buffer: -20°C, pH7.4 PBS, 0.05% NaN3, 40% Glycerol
Applications
- ELISA (ELISA)
- Western Blotting (WB)
- Immunohistochemistry (IHC)